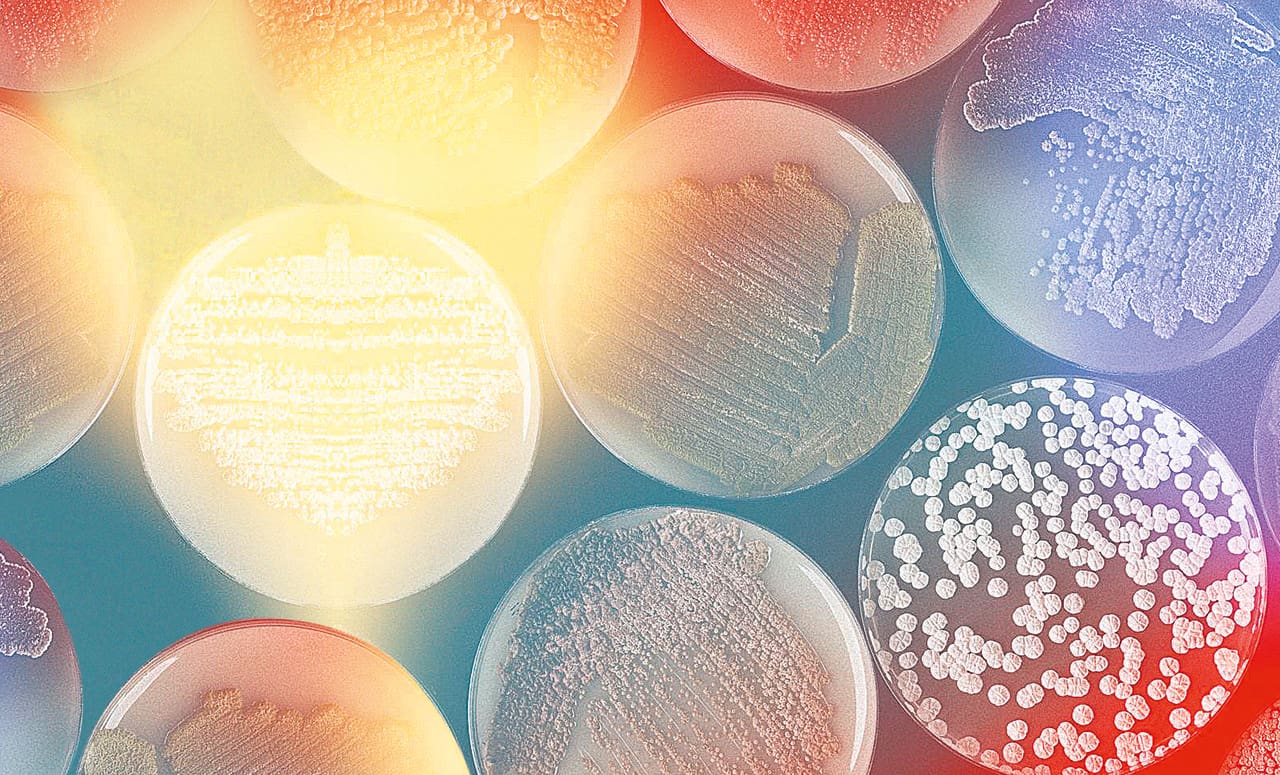

Cottonbro / Pexels
Experts are still on the fence.
We know about less than 10 percent of the living organisms on this planet and most of the ones we know significant amounts about are the ‘bad’ ones,” says beauty entrepreneur and expressive biology advocate Jasmina Aganovic. “That is a terrible way to judge an entire ecosystem.”
As chemical biology engineer, founder of skin probiotic company Mother Dirt, and CEO of biotech beauty company Arcaea, Aganovic is on a mission. She wants more people to work with their own microbiomes—the living organisms that form various ecosystems in the body—to alleviate skin problems.

In the last few years, there has been a spirited discussion and more awareness in keeping our microbiomes as balanced as possible for beauty benefits and our own general health.
“The more we see how many microorganisms have been working invisibly to critically support life, the more our framing here can change,” Aganovic says, adding that pathogenicity, or the potential ability to produce disease, is still very real. “Understanding how to avoid harmful microbes was critical to human health, but it’s only a small portion of the picture.” Her prebiotic acne lotion with Mother Dirt has had raving reviews, claiming that it has cleared their skin in a short span of time.
With Arcaea, Aganovic is taking it a step further by growing new ingredients through DNA sequencing, fermentation, and bio-engineering.
“Arcaea’s mission is to use expressive biology to unlock the benefits of natural molecules in the entire tree of life that were previously inaccessible,” she says. “We are not just seeking to create replacements, but that we are seeking to create new ingredients and functionality. This enables a new slate of tools for self-expression and shifts the supply chain away from depleting natural resources.”
Waiting for the science
Exciting as they may be, many dermatologists in the Philippines remain careful with products targeted at the skin’s microbiome.
“Studies are really lacking at this point,” Dr. Benjamin Bince, a longtime dermatologist practicing in the Philippines and the UAE, tells Vogue Philippines. “We only know what’s there, but how much we need of what, the composition—it still needs further medical studies.”
Bince adds that microbiomes are highly individualistic, making it difficult to accept—at least for the time being— products for a wide range of consumers. “The composition of one’s microbiome is dependent on so many factors,” he says. “One’s race, the climate, and their environment are just a few that come into play.”
Asians have different organisms living on the skin compared to Caucasians and even among Asians, diet can come into play.
Gut first
What’s been proven so far are the benefits of having healthy microflora in the gut, especially with the enduring popularity of probiotic drinks. But awareness to microbiomes in other parts of the body, however, is relatively new, and the added attention to it was probably bolstered during the pandemic. In the Philippines, there are doctors who are also putting the spotlight on the preventive and functional branches of medicine.
Dr. Kaycee Reyes, a dermatologist who also has a masters in preventive medicine from Germany, is one who’s open into integrating research on microbiomes into her practice at her clinic, Luminisce. “It’s not just about the aesthetic and the outside, diseases are coming from within,” she says.

Treating her patients for their skin concerns, from acne to psoriasis, means going for a more holistic and personal approach, even taking one’s lifestyle into consideration. “I often prescribe oral probiotics and prebiotics to patients, especially those whose concern is acne, but topical probiotics aren’t my first line of defense,” Reyes says. “There aren’t enough studies on topical probiotics for the skin’s microbiome yet and while—in my opinion—they may help treat skin issues like psoriasis for some time, they won’t fully get rid of the issue.”
Keeping your gut’s microflora balanced is actually a nobrainer. Uninterrupted sleep for six to eight hours, eating well, leading an active lifestyle, and meditation which improves breathing are just some of the things Reyes recommends.
Centro Holistico’s Dr. Candy Drilon-Dalman, a medical and functional doctor, has also been busy promoting gut health and complementary treatments to some of the most common diseases since 2014.
Fresh from an anti-aging congress in Thailand, Dalman says there is major interest in biohacking the skin, which heavily involves the gut’s microbiome. Traditional medical treatments like acupuncture and colon cleansing are just some of the things she’s recommended to patients with gut and skin concerns.
“They work, especially as complementary treatments—and the effects aren’t just seen on the skin,” she says. “A healthy gut affects so many bodily functions. It even contributes to better mental health.”
Dalman agrees with Reyes’ recommendations that start with care from within, adding that exposure to nature can also help in one’s journey to better skin and even strengthening the immune system. Exposing your skin’s microbiome to nature gives you better access to organisms your body will be happy to host.
“Forest bathing is great, step on grass with bare feet some time,” she recommends. “The world is not supposed to be sterile. Constant usage of alcohol on the skin and spraying one’s surroundings also kills the good bacteria.” Dalman has also ventured into the use of probiotic skincare and says she is personally seeing results.

Meanwhile, there are studies on topical probiotics preventing the growth of certain pathogens on the skin, Reyes adds. But she currently sees them as an add-on to medicine and other proven treatments.
While waiting for further studies on the skin’s microbiome, all three doctors recommend keeping the gut in check. Bince adds that before taking supplements, it’s also best to consult with a doctor first because any type of overgrowth—even of good bacteria—can also lead to an imbalance. Dalman meanwhile, adds that for those in the clear to take oral probiotics as supplements, what would work best for Filipinos are the ones made in Asia, especially Thailand, which enjoys a similar climate and environment as the Philippines.
All-in-all, it feels like the way to go is to go back to the basics of health. “It’s about understanding biology, the basis of life,” Aganovic says. She admits that more scientific studies are needed and they’re working on that now while she holds her ground that expressive biology is the future.
“Our name comes from the root ‘ancient’ and ‘to lead the way,’ a paradox that acknowledges the fundamental premise of Arcaea: to look to nature’s most powerful and primordial technology to engineer a more stable future. To go forward, we must go back.
This article was previously published in Vogue Philippines’ October 2022 issue.
